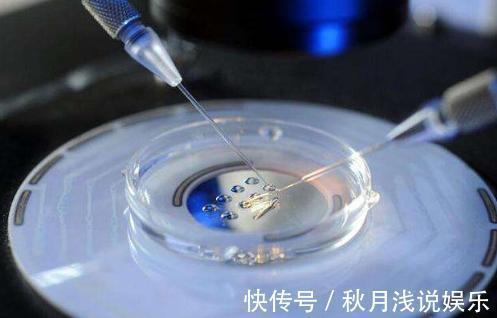
试管婴儿|做试管婴儿究竟有多疼?看完才知道当妈妈多不容易,赶紧孝顺吧!

试管婴儿|做试管婴儿究竟有多疼?看完才知道当妈妈多不容易,赶紧孝顺吧!
做试管婴儿究竟有多疼?看完才知道当妈妈多不容易,赶紧孝顺吧!
【 试管婴儿|做试管婴儿究竟有多疼?看完才知道当妈妈多不容易,赶紧孝顺吧!】
文章插图
每一位母亲都是既平凡而又伟大的,自从十月怀胎开始,母亲就要承受着各种各样的折磨,直到把孩子生下来,噩梦才结束。不过,能够顺利生下孩子的母亲,已经是很幸运的了。要知道,还有多少相当妈又怀不上的女人啊!

文章插图
因为一些生理问题,有些母亲想当妈却又怀不上,无奈她们只好选择做试管婴儿了。试管婴儿看似简单,仿佛也不要承担什么痛苦,但是只有经历过的妈妈才知道试管婴儿究竟有多疼。下面就一起跟着小编来看看,做试管婴儿到底要承担着哪些痛苦吧!1、疏通输卵管在给准妈妈做试管婴儿之前,医生会对准妈妈进行一系列的身体检查,检查准妈妈的输卵管是否堵塞,一旦准妈妈的输卵管堵塞,那么就必须进行疏通了。而这种疏通将是非常疼痛的,一搞不完,那种折磨,准妈妈就会一个星期下不了床。
文章插图
2、取卵之痛医生在给准妈妈取卵的时候,准妈妈要经历的痛苦才是非同寻常的。通常女性排卵都会每月一排,但是为了增加受孕的成功率,医生会给准妈妈打促进排卵的针,让准妈妈派出多个卵细胞。在取卵的时候,医生会将一根针直接插入到女性的身体之中,然后对卵巢里的卵细胞进行抽取,这个痛苦仿佛钻心,只有体会过的女人才知道,究竟有多痛。

文章插图
3、植入之痛去除卵细胞之后,医生就会将它和优质的精子相结合,然后在试管中完成融合,之后等到受精卵形成成熟的胚胎之后,再移植进入母体中继续生长。而移植胚胎的过程,对于孕妈来说,无疑又是一次巨大的痛苦。其痛苦堪比分娩,许多女星在移植完试管婴儿之后,几天都下不了床,可见该有多痛。

文章插图
4、打激素针将胚胎移植准妈妈的体内之后,为了促进胎儿的成长,准妈妈还必须忍受着多次激素针的折磨,才能帮助其受孕成长,对于女性来说,不仅是身体上,还有心灵上全都是煎熬。

文章插图
5、体检胎儿在孕妈的身体里成长之后,准妈妈还要经常体检、验血、验尿,以保证胚胎的正常生长,其过程比一般的孕妈都要复杂困难得多!

文章插图
6、分娩可别以为,试管婴儿孕妈就不要分娩了。胚胎在孕妈的体内长大之后,孕妈一样要经受分娩之苦。而且此时的孕妈,要比一般的孕妈所承担的痛苦还要多!无论是身体,还是心灵上,孕妈都要经历更大的折磨。而分娩对于孕妈而言,将是人生中最大的一个挑战!

文章插图
- 原生家庭|“无腿妈妈”不听劝阻,坚持做试管生下双胞胎,6年后过得怎么样
- 孩子睡觉时,究竟该不该穿袜子?新手宝妈多注意,别做糊涂事!
- 孩子|女儿逛街要抱抱,“懒爸”的做法让人笑喷了,网友:绝对亲生的
- 坐月子|“坐月子”究竟是坐30天还是42天?听听妇科专家怎么说
- 有种伤害叫妈妈做的“偷懒辅食”,看似娃很接受,实则有积食风险
- 试管婴儿|试管婴儿“寿命不过40、智商低,还易患病”?有一个或许是真的!
- 男子发现邻居“女儿”越来越像自己,偷做亲子鉴定,结果不淡定了
- 孩子|一位10岁男孩的早晨火了,刺痛无数父母内心:别再做“毒”父母
- 怎样知道胎儿在子宫里是睡着还是醒的,胎儿醒着的时候会做什么?
- 最伤害孩子的“中国式礼貌”,你逼孩子做了吗?